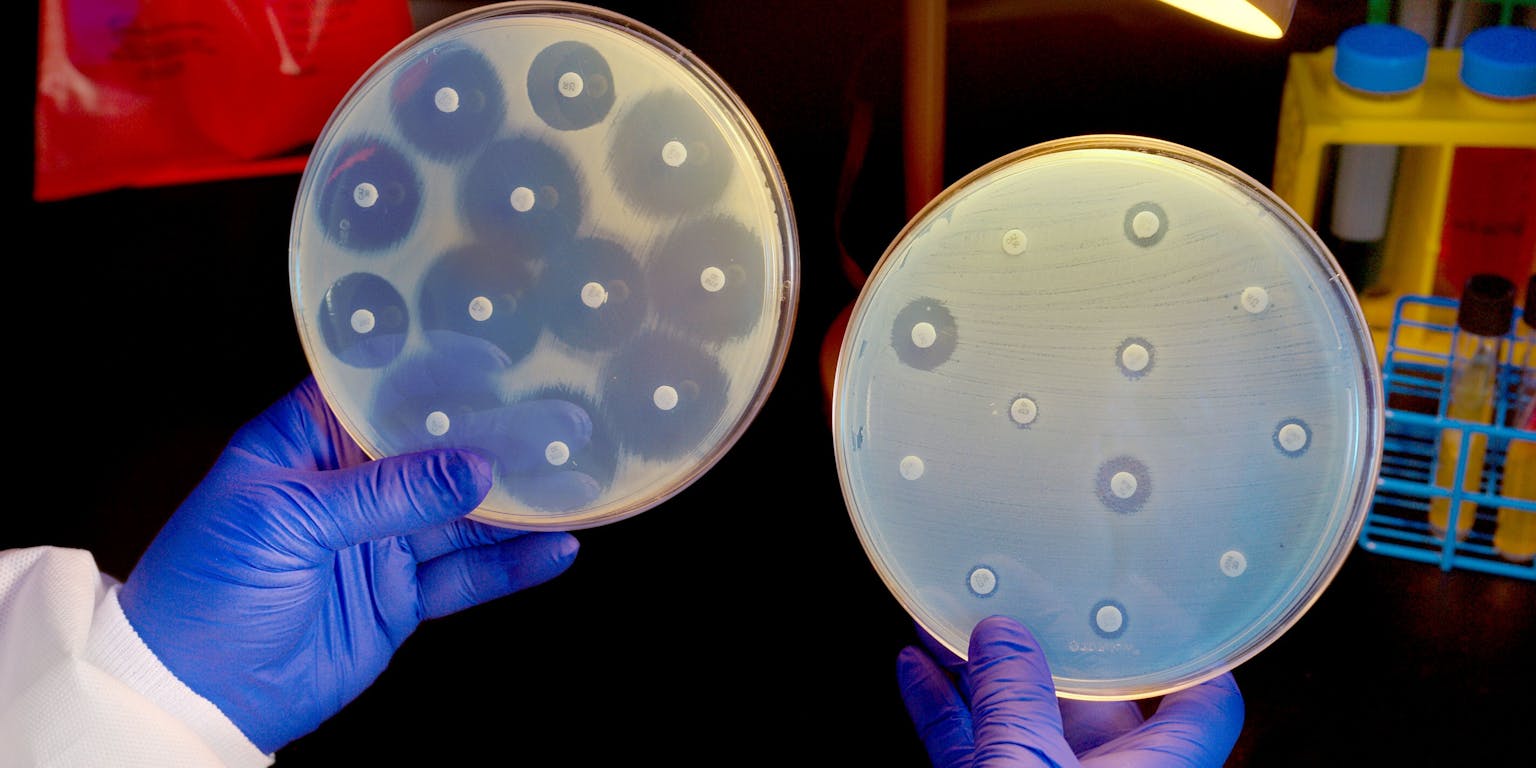
Een antibiogram. De grootte van de cirkels om de gekleurde tabletjes geeft aan in hoeverre een bacterie gevoelig is voor de antibiotica.

Sinds mensenheugenis is er naar middelen gezocht die infecties kunnen bestrijden, hoewel men in het verre verleden nog niet precies wist wat een infectie was. Men herkende wel bepaalde ziektebeelden, zoals een wond waar pus uit kwam waarna iemand koorts kreeg en stierf, óf beter werd. Dat laatste probeerde men te versnellen door natuurlijke preparaten toe te dienen, bijvoorbeeld honing of kruiden.
Pas een paar honderd jaar geleden, nadat Anthonie van Leeuwenhoek de eerste eencellige micro-organismen had ontdekt en Duitse arts Robert Koch het verband legde tussen eencelligen en het ontstaan van bepaalde ziektebeelden, werd duidelijk dat infectieuze ziektebeelden meestal werden veroorzaakt door bacteriën en virussen.
Ook werd geleidelijk aan duidelijk waarom bacteriële infecties wel en virale infecties niet te behandelen waren met antibiotica. Bacteriën en virussen vermenigvuldigen zich namelijk op een heel andere wijze en maken ons daardoor op een heel andere manier ziek. Dit is van wezenlijk belang voor de behandeling met antibiotica en indirect ook voor het ontstaan van antibioticaresistentie.
Antibiotica verstoren of remmen levensprocessen in de bacterie
Er zijn in de loop van de jaren veel soorten antibiotica ontdekt die op verschillende manieren belangrijke levensprocessen in bacteriën verstoren en ze daarmee in groei remmen of doden. Een eerste grote groep, de beta-lactam-antibiotica, is gericht op de vernietiging van de bacteriële celwand.
Bacteriën hebben een celwand om zich als eencelligen te kunnen handhaven in de buitenwereld. Menselijke cellen hebben geen celwand nodig. De mens, een meercellig wezen, heeft gespecialiseerde huid- en slijmcellen om zich tegen invloeden van buiten te beschermen. De bouwstenen voor de bacteriële celwand en de celwandsynthese – de machinerie in de bacteriecel om de celwand te maken – zijn daardoor een ideaal doelwit voor antibiotica. Beta-lactam-antibiotica grijpen direct in op de structuur van de celwand van bacteriën, waardoor ze sterven.
Een tweede grote groep antibiotica, de aminoglycosiden, remmen de eiwitsynthese zodat bacteriën geen eiwitten of enzymen meer kunnen maken die ze nodig hebben om te overleven. Een derde belangrijke groep antibiotica – de chinolonen – grijpt direct in op het DNA van de bacterie en de wijze waarop bacteriën DNA vermenigvuldigen. Ook dit proces verloopt anders dan bij de mens.

Aangrijpingspunten voor antibiotica in de bacteriële cel en resistentiemechanismen ontwikkeld door bacteriën.
Biowetenschappen en Maatschappij, Wikimedia CommonsHelaas werken lang niet alle antibiotica tegen alle bacteriën. Ook bacteriesoorten verschillen onderling in celopbouw, waardoor een antibioticum meer of minder specifiek werkt. Een bacterie wordt ‘gevoelig’ voor een antibioticum genoemd wanneer de bacterie niet overleeft bij antibioticumconcentraties die bereikt worden in de mens na het toedienen, en ‘resistent’ wanneer het deze concentraties wel overleeft. Sommige bacteriesoorten zijn van nature al resistent tegen bepaalde antibiotica, andere kunnen deze resistentie verwerven.
De reden dat antibiotica niet werken tegen virussen en virusinfecties, is vrij eenvoudig: de aangrijpingspunten voor antibiotica ontbreken bij virussen. Virussen hebben namelijk geen celwand of machinerie voor eiwitsynthese: ze vermenigvuldigen zich via menselijke cellen. Griep en verkoudheid zijn dus niet met antibiotica te bestrijden.
Resistentie ontstaat continu: een kwestie van mutatie en selectie
Bacteriën delen zich snel en vaak. Sommige wel elk half uur. Na twaalf uur delen en groeien zijn ze al met 10 miljoen. Bij een infectie gaat het dan al snel om 100 miljoen bacteriën of meer. Voor elke celdeling moet het DNA gedupliceerd worden en bij elke verdubbeling treden spontaan wel een of meer foutjes op in het DNA: de mutaties.
Meestal heeft dat geen gevolgen voor de bacteriepopulatie als geheel, de bacteriecel met DNA-mutaties gaat dood of wordt overgroeid door bacteriecellen waar geen mutatie optrad. De meeste mutaties zijn ook meestal nadelig voor de betreffende bacterie waardoor deze niet overleeft. Deze spontane mutaties vinden continu plaats, zonder bepaald patroon.
Wanneer de bacterie zich in een omgeving bevindt waar ook een antibioticum aanwezig is, en de mutatie geeft de bacterie een grotere overlevingskans, dan zal deze bacterie zich beter handhaven en vermenigvuldigen dan bacteriën zonder de mutatie(selectie). De andere gevoelige bacteriën sterven, en de mutant overleeft volgens het Darwinistische principe survival of the fittest. Resistente bacteriën ontstaan continu, alleen wanneer er ook antibiotica aanwezig zijn, hebben zij voordeel en kunnen gaan overheersen. Hoe vaker en hoe meer antibiotica worden gebruikt, hoe groter de kans dat resistente bacteriën zullen verschijnen.
Dankzij de mutaties kunnen bacteriën dus soms over resistentiemechanismen beschikken die antibiotica onschadelijk maken. Er zijn veel verschillende mechanismen bekend. Sommige bacteriën produceren specifieke enzymen, zoals beta-lactamases, die antibiotica afbreken. De afbraak kan buiten de cel of binnen de cel gebeuren. Beiden komen veel voor.
Een ander veel voorkomend resistentiemechanisme is een verandering van het aangrijpingspunt van het antibioticum, bijvoorbeeld de verandering van de eiwitstructuur van de enzymen die betrokken zijn bij de opbouw van de celwand. Een simpele puntmutatie, waardoor een ander aminozuur in het eiwit wordt ingebouwd, kan zo direct voor resistentie zorgen. Vergelijkbare mechanismes zijn ook binnen de cel te vinden, bijvoorbeeld veranderingen in de eiwitstructuur van het ribosoom waar een bepaald antibioticum op inwerkt.
Van mens op mens en van bacterie op bacterie
Antibioticaresistentie kan zich op twee belangrijke manieren verspreiden. Ten eerste van mens op mens. Mensen dragen direct of indirect bacteriën aan elkaar over (transmissie). Dit geldt ook voor resistente bacteriën. Iemand hoeft daarvoor zelf niet ziek te zijn, hij of zij is dan alleen drager van resistente bacteriën. Iemand die de resistente bacterie ontvangt en gekoloniseerd raakt, hoeft dus niet ziek te worden, maar kan de resistente stam wel weer doorgeven.
Pas wanneer de resistente bacterie binnendringt (invasief) en schade toebrengt, is er sprake van een infectie. Deze infectie kan dan niet meer behandeld worden met het betreffende antibioticum. Door de combinatie van selectiedruk en overdracht van bacteriën tussen mensen ontstaat uiteindelijk resistentie in een bevolkingsgroep als geheel.
Resistentie kan zich ook van bacterie op bacterie verspreiden. Door het uitwisselen en/of opnemen van DNA kunnen gevoelige bacteriën de resistentiemechanismen van resistente bacteriën verwerven. Wanneer antibiotica in de omgeving aanwezig zijn, zullen deze resistente bacteriën zich verder verspreiden ten koste van de gevoelige bacteriën. Deze manier begint een steeds belangrijkere rol te spelen in de verspreiding van resistentie.
Het voorkomen van resistentie
De vraag is nu: hoe kunnen we selectie van resistente stammen en de verspreiding daarvan voorkomen? Het antwoord is eenvoudig: het zo beperkt mogelijk voorschrijven en gebruiken van antibiotica en de infectiepreventiemaatregelen in acht nemen. Met andere woorden: het verminderen van selectiedruk en transmissie op elk niveau. Voorkomen is beter dan genezen. Voor het eerste zijn er in Nederland, en ook daarbuiten, voorschrijfrichtlijnen waaraan artsen zich moeten houden. Deze zijn zodanig opgesteld dat enerzijds de behandeling zo optimaal mogelijk is maar anderzijds de selectiedruk zo beperkt mogelijk wordt gehouden.
Voor het voorkomen van verspreiding zijn er in ziekenhuizen veel richtlijnen opgesteld waaronder het steriel werken in operatiekamers, het goed handenwassen na handenwassen na patiëntencontact en in sommige extreme en in sommige extreme gevallen het isoleren van de patiënt om het risico op verspreiding zoveel mogelijk in te perken. Ook patiënten zelf spelen een belangrijke rol, bijvoorbeeld door niet onnodig antibiotica te slikken bij een virusinfectie, waardoor de selectiedruk vermindert.